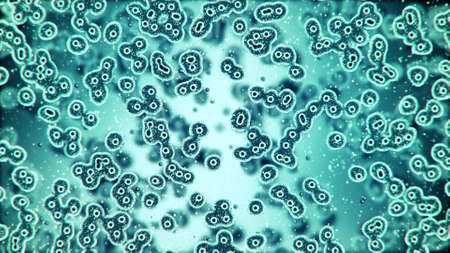
Microscopic plate of bacteria multiplying themselves 3d renderingの写真素材

写真素材 - Microscopic plate of bacteria multiplying themselves 3d rendering
作品情報
Microscopic plate of bacteria multiplying themselves 3d rendering
- ID:98119616
- 作品種別:写真
- 作者名:irochka
キーワード
- 3d
- 3d rendering
- abstract
- aids
- background
- bacteria
- bacterium
- biology
- blood
- blue
- cancer
- cell
- clone
- close-up
- disease
- dna
- epidemic
- hazard
- health
- hiv
- illness
- infection
- lab
- laboratory
- life
- macro
- medical
- medical exam
- medicine
- micro
- microbe
- microbiology
- microscope
- motion
- multiplying
- nucleus
- organic
- organism
- plate
- research
- rna
- science
- scientific
- sickness
- small
- system
- themselves
- virus
- Microscopic
類似作品
Smear of Gram's...
Beautiful micro...
Backgrounds of ...
Backgrounds of ...
Backgrounds of ...
Lichen and fung...
Smear of Positi...
Air bubbles ins...
Backgrounds of ...
Backgrounds of ...
Bacteria coloni...
Bacterial colon...
microscope lens...
A petri dish wi...
Backgrounds of ...
Mycobacterium t...
Backgrounds of ...
Colonies of mic...
Agar plate with...
Backgrounds of ...
Backgrounds of ...
abstract backgr...
A researcher in...
Backgrounds of ...
Backgrounds of ...
Bacterial colon...
Mixed of bacter...
Staphylococcus ...
Bacterial cultu...
Smear of positi...
Backgrounds of ...
Backgrounds of ...
Two Petri dishe...
Hand in glove h...
Backgrounds of ...
Staphylococcus ...
Petri dish whit...
stool specimen ...
Black bacterial...
Bright overgrow...
Smear of Gram's...
Colony Characte...
Backgrounds of ...
Slide sputum AF...
Red on a blue. ...
Bacterial colon...
Backgrounds of ...
Petri dishes wi...
Backgrounds of ...